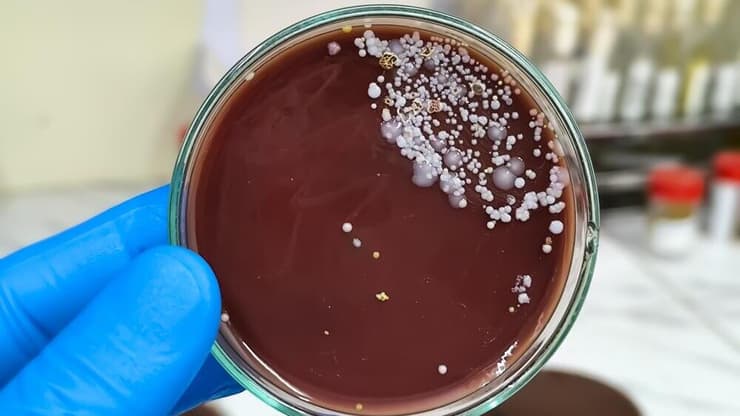
קנדידה אוריס (Candida auris)

בשעה שהעולם מתמודד עם אתגרי בריאות משתנים, פתוגן חמקמק אך אלים במיוחד מעורר דאגה גוברת בקרב גורמי רפואה ברחבי העולם. קנדידה אוריס (Candida auris) היא פטרייה פולשנית ממשפחת הקנדידה, שזוהתה לראשונה ביפן בשנת 2009, ומאז הפכה לאחד האיומים המדאיגים ביותר על מערכות הבריאות, במיוחד בבתי חולים ובבתי אבות.
על פי נתונים עדכניים של המרכזים לבקרת מחלות ומניעתן (CDC) בארה"ב, נכון לסוף שנת 2025 נדבקו בפטרייה יותר מ-7,000 בני אדם ב-27 מדינות ברחבי ארצות הברית, והיא כבר תועדה ביותר מ-61 מדינות בשש יבשות - נתון שמעיד על התפשטות גלובלית מואצת ועל פוטנציאל סיכון משמעותי לבריאות הציבור.
פרופ' אייל לשם, מומחה למחלות זיהומיות מהמרכז הרפואי שיבא תל השומר, מסביר כי קנדידה אוריס היא פטרייה שמעוררת דאגה רבה בעיקר משום שהיא פוגעת באוכלוסיות מוחלשות, שאצלן היכולת להתמודד עם זיהומים מוגבלת מלכתחילה, וכן משום שהטיפול בה מורכב יותר. לדבריו, הפטרייה מתפשטת בעיקר בסביבות רפואיות, ובפרט בבתי חולים ובבתי אבות - היבט שהופך אותה לאיום משמעותי עבור מערכות הבריאות.
באשר לישראל, פרופ' לשם מדגיש כי לא מדובר בתרחיש תיאורטי: "הפטרייה קיימת גם בארץ. כאשר היא מזוהה אצל מטופל מאושפז, ננקטים אמצעי בידוד קפדניים ואמצעי מיגון, במטרה למנוע הדבקה של חולים אחרים. עם זאת, המחלקות בבתי החולים בישראל, ובעיקר המחלקות הפנימיות, סובלות מצפיפות גבוהה - במיוחד בחודשי החורף - מצב שמעלה משמעותית את רמת הסיכון".
פרופ' אייל לשם צילום: יעקב לויט, יחידת צילום שיבאלמה היא נחשבת ל"סופר-באג"?
לדברי פרופ' לשם, מה שהופך את קנדידה אוריס למסוכנת במיוחד הוא העמידות יוצאת הדופן שלה לטיפולים תרופתיים. "היכולת להשתמש בתרופות אנטי-פטרייתיות לטיפול בזיהומים הנגרמים ממנה מוגבלת יותר בהשוואה לפטריות אחרות. לכן, מושם דגש על זיהוי מוקדם של נשאים - גם בשלב שבו הפטרייה נמצאת על הגוף מבלי לגרום לנזק - כדי לבודד אותם ולמנוע הפצה למטופלים אחרים. אמנם קיימות אפשרויות טיפול, אך ביחס לפטריות שמר אחרות, קנדידה אוריס נחשבת לעמידה במיוחד".
המסוכנות של קנדידה אוריס נובעת מיכולתה לפתח מנגנוני הישרדות מתוחכמים במיוחד. על קרום התא של הפטרייה קיימות מערכות ייחודיות, המכונות "משאבות פליטה", המסוגלות לסלק תרופות אנטי-פטרייתיות מתוך התא עוד לפני שהן מספיקות לפעול, וכך להקנות לה עמידות גבוהה לטיפול תרופתי.

בנוסף, הפטרייה מייצרת חלבונים המאפשרים לה להיצמד לעור האדם בעוצמה, כמעט "כמו דבק", תכונה שמקלה על העברתה בין חולים בתוך בתי חולים ובתי אבות. בשונה מפטריות רבות אחרות, קנדידה אוריס מסוגלת לשרוד זמן ממושך על משטחים קשיחים – כגון מעקה של מיטה, ציוד רפואי ושלטים - ואינה מושמדת בקלות באמצעות חומרי חיטוי שגרתיים. שילוב תכונות זה הופך אותה לאתגר משמעותי עבור מערכות הבריאות ולגורם סיכון מתמשך בסביבות אשפוז.
מי נמצא בסיכון ומהם התסמינים?
עבור אנשים בריאים, הפטרייה בדרך כלל אינה מהווה סכנה מיידית והגוף מסוגל להילחם בה. עם זאת, בקרב אוכלוסיות פגיעות המאושפזות בבתי חולים או בבתי אבות, מדובר בסכנת מוות. ה-CDC מעריך כי שיעור התמותה מהזיהום נע בין 30% ל-60%, אם כי לרבים מהחולים יש מחלות רקע קשות נוספות.
התסמינים קשים לזיהוי משום שהם דומים מאוד לזיהומים חיידקיים רגילים: חום גבוה, צמרמורות ותשישות שאינם מגיבים לטיפול אנטיביוטי. לעיתים קרובות המעבדות טועות באבחון ומזהות אותה כסוג אחר של קנדידה, מה שמוביל לעיכוב קריטי בטיפול הנכון.
לפי "The Hill", מדענים, בהם פרופ' ארטורו קסדבל מאוניברסיטת ג'ונס הופקינס, מעלים תיאוריה מרתקת ומדאיגה: שינויי האקלים הם שדחפו את הפטרייה להפוך לאיום אנושי. היסטורית, פטריות התקשו לשרוד בטמפרטורת הגוף האנושי. אך ככל שהעולם מתחמם, הפטריות מסתגלות לטמפרטורות גבוהות יותר. ברגע שהן חוצות את "מחסום הטמפרטורה", גוף האדם כבר אינו סביבה עוינת עבורן, והן מצליחות לשגשג בתוכו.
למרות התמונה הקודרת, החוקרים ותעשיית הפארמה אינם עומדים מנגד. בשנת 2023 אישר ה-FDA את התרופה Rezafungin לטיפול בזיהומי קנדידה פולשניים, וישנן תרופות נוספות בשלבי פיתוח מתקדמים. בנוסף, חלה התקדמות בפיתוח חיסונים שעשויים להגן על קבוצות סיכון מפני מגוון רחב של פטריות.
גורמי הבריאות מדגישים כי המפתח לבלימה הוא היגיינה קפדנית במוסדות רפואיים, בידוד חולים נשאים ושימוש בחומרי חיטוי ייעודיים.